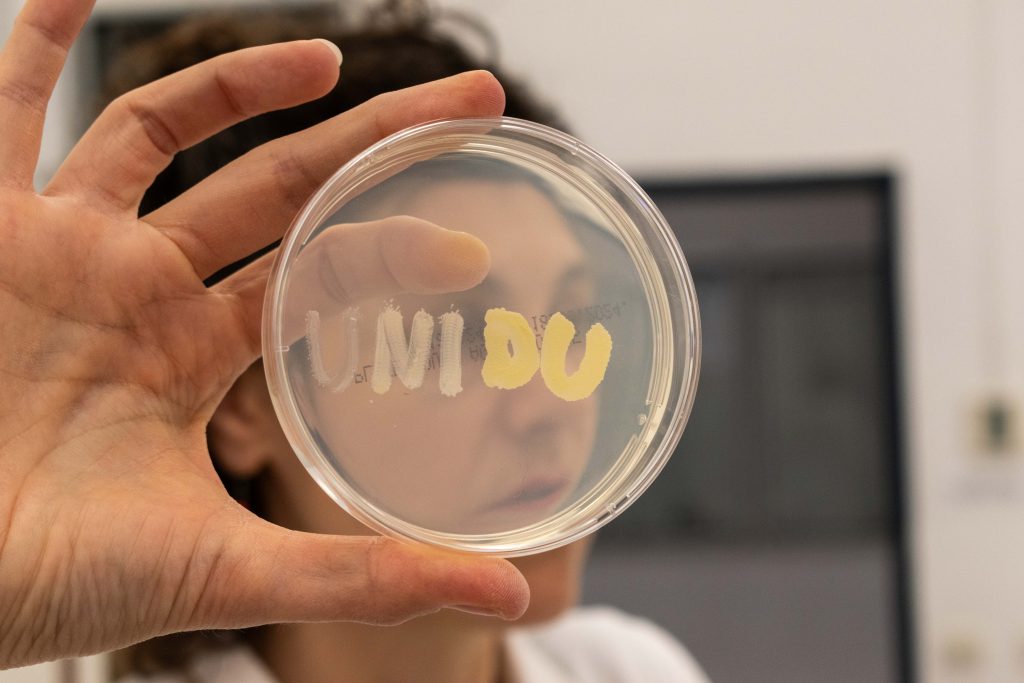

- UNIDU
- STUDIJI
- Upisi
- Prijediplomski studij
- Nautika
- Brodostrojarstvo
- Pomorske tehnologije jahta i marina
- Ekonomija
- Poslovna ekonomija smjer IT menadžment
- Poslovna ekonomija smjer Marketing
- Poslovna ekonomija smjer Međunarodna trgovina
- Poslovna ekonomija smjer Turizam
- Hotelijerstvo, restoraterstvo i gastronomija
- Financijski menadžment
- Elektrotehničke i komunikacijske tehnologije u pomorstvu
- Primijenjeno/poslovno računarstvo
- Primijenjena ekologija mora
- Mediji i kultura društva
- Konzervacija-restauracija
- Sestrinstvo
- Povijest Jadrana i Mediterana
- Diplomski studij
- Pomorstvo
- Ekonomija
- Poslovna ekonomija smjer IT menadžment
- Poslovna ekonomija smjer Marketing
- Poslovna ekonomija smjer Turizam
- Hotelijerstvo
- Financijski menadžment
- Elektrotehničke i komunikacijske tehnologije u pomorstvu
- Primijenjeno/poslovno računarstvo
- Marikultura
- Mediji
- Odnosi s javnostima
- Konzervacija-restauracija
- Kliničko sestrinstvo
- Double Degree diplomski studijski program na engleskom jeziku / ekonomija / marketing / turizam
- Poslijediplomski studij
- Cjeloživotno učenje
- STUDENTSKI ŽIVOT
- ZNANOST
- SURADNJA
- UNIDU
- ENG